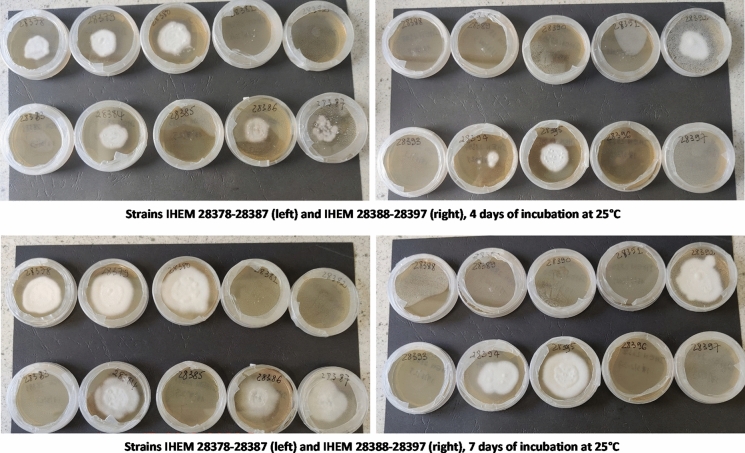

Abstract
The emerging pathogen Trichophyton indotineae, often resistant to terbinafine (TRB), is known to cause severe dermatophytoses such as tinea corporis and tinea cruris. In order to achieve successful treatment for these infections, insight in the resistance profile of T. indotineae strains and rapid, reliable identification is necessary. In this research, a screening medium was tested on T. indotineae strains (n = 20) as an indication tool of TRB resistance. The obtained results were confirmed by antifungal susceptibility testing (AST) for TRB following the in vitro broth microdilution reference method. Additionally, AST was performed for eight other antifungal drugs: fluconazole, itraconazole, voriconazole, ketoconazole, griseofulvin, ciclopirox olamine, naftifine and amorolfine. Forty-five percent of the strains were confirmed to be resistant to terbinafine. The TRB resistant strains showed elevated minimal inhibitory concentration values for naftifine and amorolfine as well. DNA sequencing of the squalene epoxidase-encoding gene showed that TRB resistance was a consequence of missense point mutations in this gene, which led to amino acid substitutions F397L or L393F. MALDI-TOF MS was used as a quick, accurate identification tool for T. indotineae, as it can be challenging to distinguish it from closely related species such as Trichophyton mentagrophytes or Trichophyton interdigitale using morphological characteristics. While MALDI-TOF MS could reliably identify ≥ 95% of the T. indotineae strains (depending on the spectral library), it could not be used to successfully distinguish TRB susceptible from TRB resistant strains.
Keywords: Trichophyton indotineae, Medical mycology, Antifungal susceptibility testing, MALDI-TOF MS, Terbinafine, Naftifine, Amorolfine, Dermatophytosis
Introduction
Dermatophytes are filamentous, keratinophilic fungi of the Arthrodermataceae family that are able to infect the skin, hair and nails of humans and animals. The superficial infections caused by this group of fungi are called dermatophytoses, or more frequently ringworm. Dermatophytes are generally categorized in three groups based on their primary habitat: zoophilic species are associated with animals and anthropophilic species specifically with humans, while geophilic species are associated with soil and the keratinous materials that can be found in it, such as animal hairs, feathers and horns [1, 2]. Most skin mycoses are caused by dermatophyte species belonging to the anthropophilic and zoophilic categories, and more specifically belonging to genera Trichophyton and Microsporum. Despite the superficial nature of mycoses, dermatophytes are a serious global health problem. The prevalence of skin diseases caused by dermatophytes is high: 20–25% of the global population has been estimated to suffer from these skin mycoses [3]. In addition to this common incidence, treatment of these mycoses have a considerable therapeutic cost and are a significant burden to health care systems [4, 5].
The past few years, an epidemic of skin mycoses plagued and, to this day, still affects India and its neighbouring countries. Patients mainly suffer from tinea corporis, tinea cruris or tinea faciei, demonstrating highly inflammatory lesions which are often difficult to treat [6, 7]. The causal agent of this Indian epidemic was labeled Trichophyton mentagrophytes genotype VIII after sequencing of the internal transcribed spacer (ITS) region of the ribosomal DNA. Kano et al. (2020) later reclassified the pathogen as being a separate species from T. mentagrophytes/T. interdigitale, naming the new dermatophyte T. indotineae [7–10]. Although T. indotineae is morphologically not distinguishable from T. mentagrophytes, it is transmitted from person to person and thus, anthropophilic, while T. mentagrophytes is a zoophilic species. T. indotineae also displays differences in physiology with T. mentagrophytes and T. interdigitale: the capacity to perforate hair and to hydrolyze urea is significantly lower in T. indotineae than in T. mentagrophytes and T. interdigitale [9]. Last but not least, the high level of resistance to the antifungal drug terbinafine is characteristic for T. indotineae. The elevated prevalence of terbinafine-resistant T. indotineae isolates can be attributed to the frequency of amino acid substitutions in squalene epoxidase at position 393 or 397 (L393F, leucine to phenylalanine; and F397L, phenylalanine to leucine), which result from point mutations in the squalene epoxidase-encoding gene (SQLE) [8, 11]. The observed terbinafine resistance is thought to be a consequence of excessive use of creams containing antifungal agents (such as terbinafine and azoles) and topical steroids (glucocorticoids such as clobetasol), that are sold over the counter in pharmacies, without the need for a doctor’s prescription [10].
Due to migration and globalization, terbinafine-resistant dermatophytoses caused by T. indotineae has been reported world-wide [10, 12–14]. In addition to its emerging prevalence over the world, it is expected that T. indotineae will be able to develop resistance to other antifungal drugs as well [8]. Elevated minimum inhibitory concentration (MIC) values of T. indotineae isolates for azoles such as itraconazole and voriconazole have already been observed [12], while cross-resistance between terbinafine and naftifine, previously described for Trichophyton rubrum [15], is not an unrealistic scenario. Therefore, to limit these complications and to avoid incorrect, long and fruitless treatment, it is vital to identify this pathogen as quick as possible and to determine if (terbinafine) resistance is present. Since conventional methods are often based on morphology and morphological differences between T. indotineae, T. mentagrophytes and T. interdigitale are minimal, other identifications methods, such as the accurate and quick Matrix-Assisted Laser Desorption/Ionization Time of Flight Mass Spectrometry (MALDI-TOF MS) identification tool, should be explored.
The first objective of this study was to gain more insight in the resistance profile of T. indotineae strains. First, a rapid screening method for TRB resistance was explored by using a selective culture medium. Secondly, antifungal susceptibility testing (AST) was performed on not only TRB, but eight other antifungal agents as well, using the in vitro broth microdilution reference method by EUCAST. These antifungal agents were fluconazole, itraconazole, voriconazole, ketoconazole, griseofulvin, ciclopirox olamine, naftifine and amorolfine. DNA sequencing of SQLE was used to support the obtained AST results. The second objective was to evaluate MALDI-TOF MS as a reliable identification tool for T. indotineae, comparing the BCCM/IHEM in-house library and the publicly accessible MSI V2.0 database.
Material and Methods
The Strains
Twenty T. indotineae strains, all originating from German patients, were isolated from the human skin between 2016 and 2019, most often causing tinea corporis or tinea cruris. The patients ages varied between 6 months and 58 years. The identity of the strains was confirmed by DNA sequencing of the ITS rDNA region (approx. 1100 bases) using primers V9G (for) and LSU 266 (rev). After sequencing, isolates were subsequently sent to the Mycology and Aerobiology unit of Sciensano (Brussels, Belgium), where they were added to the fungi culture collection of the Belgian Coordinated Collections of Microorganisms (BCCM/IHEM).
Screening Medium
All isolates were cultured on Sabouraud dextrose agar (SDA) plates containing 0.2 μg/mL of TRB (Merck, Germany) and on a drug-free control SDA plate at 25 °C [16, 17]. Presence or absence of fungal growth was evaluated every day up until 14 days after incubation on both types of medium.
Antifungal Susceptibility Testing
The antifungal susceptibility testing process was based on the protocol described by EUCAST for the broth microdilution antifungal susceptibility testing of filamentous fungi (E.DEF 9.4) [19]. Antifungal susceptibility testing of the T. indotineae strains was performed for a total of nine antifungal drugs: fluconazole, itraconazole, voriconazole, ketoconazole, terbinafine, griseofulvin, ciclopirox olamine, naftifine and amorolfine. Stock solutions of the nine antifungal drugs were prepared by dissolving the powdery drugs (Merck, Germany) in dimethyl sulfoxide (DMSO, Merck, Germany) so that the final antifungal concentrations in the microplate wells used for the inoculation of the T. indotineae strains ranged from 0.008 to 64 g/L. After inoculation of the T. indotineae strains, the microplates were incubated at 35 °C for 96 h, whereafter the MIC was visually determined at 100% inhibition of fungal growth. The microplates contained six wells with DMSO as a negative control and six without any antifungal solution as a positive control for fungal growth. Reference strains Candida krusei (ATCC 6258) and Candida parapsilosis (ATCC 22019) were used to validate the microplates. These plates were incubated at 35 °C and were read with a Biotek 96 well microplate reader (Agilent, California, USA) after 24 h of incubation.
The obtained MIC-values for the T. indotineae strains were compared to the wild-type upper limit (WT-UL) values established by Arendrup et al. [18, 19] and verified by EUCAST, as no epidemiological cut-off (ECOFF) values or clinical break points (CBP) have been put in place yet. For four antifungal drugs, i.e. itraconazole, voriconazole, terbinafine and amorolfine, WT-UL values were established, but this is not the case for the remaining five drugs.
DNA Sequencing of SQLE
DNA was extracted using an eMAG® (BioMérieux, France), after incubation of a portion of the isolate for a minimum of 10 min in Lysis buffer (BioMérieux, France). SQLE was amplified as previously described by Moreno-Sabater et al. (2022) [18, 19]. Sequences were aligned using the sequence of Trichophyton mentagrophytes isolate 203,513/19 (GenBank MT700509.1). Missense mutations were screened using MEGA X (version 10.0.5).
MALDI-TOF MS
To evaluate MALDI-TOF MS as an identification tool for T. indotineae, each strain was sub-cultured on Sabouraud agar amended with chloramphenicol (SC) and incubated at 25 °C for 72 h, after which protein extraction was performed following the method described by Cassagne et al. (2011) [20]. This method has been proven to be successful in identifying dermatophytes [21, 22]. Fungal material was gently scraped off the surface of the colonies and transferred into 300 µL of sterile water. The mixture was vortexed thoroughly and 900 µL of absolute ethanol was added subsequently. The mixture was then centrifuged for 10 min at 13 000 g, at room temperature (RT). Afterwards, the supernatant was discarded and the remaining pellet was air dried for at least 30 min, until the pellet was completely void of water. Next, the pellet was resuspended in 50 µL of 70% formic acid (Sigma-Aldrich, USA) and incubated for a minimum of five minutes at RT. The mixture was vortexed and 50 µL of acetonitrile (Sigma-Aldrich, USA) was added, again followed by an incubation period of at least five minutes at RT. The obtained suspension was centrifuged for two minutes at 13 000 g at RT. Then, 1 µL of the supernatant was pipetted onto a spot on a MALDI 96 polished steel target plate (Bruker Daltonics, Germany) and this was repeated four times (four spots per tested strain). The target plate was left to air dry at RT. After complete drying, the sample spots were covered with 1 µL of α-cyano-4-hydroxycinnamic acid (HCCA) matrix solution (in 50% acetonitrile, 47.5% water and 2.5% trifluoroacetic acid) and again, left to air dry at RT. Protein spectra were recorded with the Microflex LT (Bruker Daltonics, Germany) at standard settings, with a positive linear mode in a mass range from 2 to 20 kDa. The obtained spectra were analyzed with MALDI BioTyper 4.1 software (Bruker Daltonics, Germany) at standard settings using the in-house spectra library of the BCCM/IHEM Fungal Collection (Sciensano, Brussels, Belgium). The database contained six T. indotineae reference strains, of which three were sensitive and three were resistant to TRB. It also contained nine T. mentagrophytes strains and eleven T. interdigitale strains. The identity of all reference strains in this database was confirmed by biomolecular analysis. The MS-based identification of the tested strains was considered acceptable if the best-match log scores were ≥ 1.70 for at least three out of four spots of protein extract (with the maximum log score being 3.00).
Aside from the in-house BCCM/IHEM Fungal Collection database, the spectra were also compared to the MSI database (V2.0, accessed on 07/12/2022 in Brussels, Belgium), developed by Assistance Publique–Hôpitaux de Paris (Paris, France), Sorbonne Université (Paris, France) in collaboration with BCCM/IHEM (Sciensano, Brussels, Belgium). Since most of its reference strains were obtained after seven days of incubation and MSI results are more reliable using this incubation period, the sub-cultures of the T. indotineae strains were incubated for seven days instead of three days [23]. The remaining protocol steps for obtaining the protein spectra were identical to the one described above. The obtained identification scores with the MSI tool should exceed a threshold value of 20 for a reliable identification, only taking in account the spot with the highest score, with a score of 100 being the maximum score [24]. Identification can be up to species level (level of trust A) or up to genus level (level of trust B).
The ability of MALDI-TOF MS to differentiate TRB resistant from susceptible strains was evaluated as well. The.best-match reference strains were observed to investigate if MALDI-TOF MS would give reference strains with TRB resistance as a best-match when identifying TRB resistant sample strains and vice versa for susceptible strains. Using the in-house database, four spots were identified by MALDI-TOF MS per strain. The best-match reference strain was considered TRB resistant when at least 3 out of 4 spots had a TRB resistant best-match, and vice versa for TRB susceptible strains. When a strain had two spots with a TRB susceptible best-match and two spots with a TRB resistant best-match, it was noted that there was a 50/50 ratio TRB susceptible and resistant best-match strains. Using the MSI database, the reference strain with the highest score was considered the best-match and its susceptibility/resistance to TRB was taken into account. Susceptibility to TRB was unknown for some reference strains.
Statistical Analysis
Statistical analyses were performed in order to determine significant differences in MIC values of different groups by making use of the Mann–Whitney–Wilcoxon tests. The level of significance (p-level) was set at 0.05. The statistical and graphic design software R was used (version 4.1.2) to execute these tests.
Results
Determining TRB Resistance with a Screening Medium, AST and Sequencing of SQLE
Photos of the fungal growth of all tested T. indotineae strains at four and seven days of incubation on the TRB containing screening medium are displayed in Fig. 1.
Fig. 1.
Growth of the T. indotineae isolates on a screening medium for terbinafine resistance. The medium consists of Sabouraud dextrose agar, amended with terbinafine. The pictures displayed in the figure were taken at four and seven days of incubation at 25 °C.
In Table 1, the MIC-values per T. indotineae strain (n = 20) can be found for the nine tested antifungal agents, obtained with the in vitro broth microdilution reference method by EUCAST. The observed SQLE mutations and corresponding amino acid substitutions in these strains are also displayed in this table. The overall geometric means (GM) of the obtained MIC-values are summarized in Table 2, as well as the GM for the TRB strains considered resistant or susceptible after AST.
Table 1.
MIC-values (µg/mL) of all T. indotineae strains (n = 20) for tested antifungal agents fluconazole (FLC), itraconazole (ITC), voriconazole (VOR), ketoconazole (KET), terbinafine (TRB), griseofulvin (GRI), ciclopirox olamine (CPX), naftifine (NAF) and amorolfine (AMO). MIC-values were obtained by following EUCAST guidelines for the antifungal susceptibility testing of dermatophytes. Missense mutations in SQLE and the corresponding amino acid substitutions in the SQLE protein for the tested TRB resistant and susceptible strains. Nucleobases: thymine (T), cytosine (A), adenine (A), guanine (G). Amino acids: phenylalanine (F), leucine (L), alanine (A), threonine (T).
| T. indotineae strains | TRB resistance | MIC (µg/mL) | SQLE missense mutations | Amino acid substitution | ||||||||
|---|---|---|---|---|---|---|---|---|---|---|---|---|
| FLC | ITC | VOR | KET | TRB | GRI | CPX | NAF | AMO | ||||
| IHEM 28378 | Yes | 16 | 0.032 | 0.25 | 0.25 | 16 | 8 | 1 | 32 | 0.25 | T1189C | F397L |
| IHEM 28379 | Yes | 32 | 0.125 | 0.25 | 0.25 | 16 | 2 | 1 | 32 | 0.125 | T1189C | F397L |
| IHEM 28380 | Yes | 64 | 0.25 | 0.25 | 0.5 | 16 | 4 | 1 | 32 | 0.125 | T1189C | F397L |
| IHEM 28384 | Yes | 64 | 0.25 | 0.25 | 0.5 | 0.016 | 2 | 1 | 0.25 | 0.032 | T1189C | F397L |
| IHEM 28386 | Yes | 32 | 0.125 | 0.125 | 0.5 | 0.064 | 2 | 1 | 0.125 | 0.064 | C1191A | F397L |
| IHEM 28387 | Yes | 64 | 0.25 | 1 | 1 | 0.064 | 4 | 1 | 0.25 | 0.064 | T1189C | F397L |
| IHEM 28392 | Yes | 16 | 0.125 | 0.25 | 0.25 | 16 | 4 | 1 | 32 | 0.125 | C1191A | F397L |
| IHEM 28394 | Yes | 32 | 0.5 | 0.5 | 0.5 | 0.032 | 4 | 0.5 | 0.125 | 0.064 | A1179C | L393F |
| IHEM 28395 | Yes | 32 | 0.125 | 0.25 | 0.25 | 16 | 4 | 0.5 | 32 | 0.125 | T1189C & G1342A | F397L & A448T |
| IHEM 28381 | No | 64 | 0.25 | 0.5 | 1 | 16 | 8 | 0.5 | 32 | 0.25 | G1342A | A448T |
| IHEM 28382 | No | 8 | 0.125 | 0.125 | 0.125 | 0.064 | 2 | 1 | 0.064 | 0.064 | none | none |
| IHEM 28383 | No | 16 | 0.125 | 0.125 | 0.125 | 0.125 | 2 | 1 | 0.125 | 0.125 | G1342A | A448T |
| IHEM 28385 | No | 64 | 0.25 | 0.5 | 0.5 | 0.125 | 4 | 1 | 0.25 | 0.125 | G1342A | A448T |
| IHEM 28388 | No | 64 | 0.25 | 0.5 | 0.5 | 0.032 | 4 | 0.5 | 0.25 | 0.064 | none | none |
| IHEM 28389 | No | 64 | 0.25 | 0.25 | 0.25 | 16 | 4 | 0.5 | 32 | 0.125 | G1342A | A448T |
| IHEM 28390 | No | 16 | 0.064 | 0.125 | 0.125 | 0.064 | 8 | 0.5 | 0.5 | 0.25 | G1342A | A448T |
| IHEM 28391 | No | 32 | 0.125 | 0.25 | 0.125 | 16 | 2 | 0.5 | 16 | 0.25 | G1342A | A448T |
| IHEM 28393 | No | 64 | 0.25 | 0.125 | 0.25 | 16 | 8 | 0.5 | 32 | 0.25 | G1342A | A448T |
| IHEM 28396 | No | 32 | 0.25 | 0.25 | 0.5 | 0.032 | 2 | 0.5 | 0.25 | 0.25 | G1342A | A448T |
| IHEM 28397 | No | 16 | 0.064 | 0.125 | 0.125 | 0.032 | 2 | 0.5 | 0.064 | 0.125 | G1342A & G1330A | A448T |
Table 2.
Geometric means (GM) of the MIC-values of all T. indotineae strains, and separately for the terbinafine (TRB) resistant and susceptible strains. Asterisks (*) symbolize a significant difference between the GM MIC-values of TRB susceptible and resistant strains, after statistical analysis (Mann–Whitney–Wilcoxon test, p = 0.05).
| Antifungal agent | GM MIC-values (mg/L) | ||
|---|---|---|---|
| All strains (n = 20) | TRB susceptible strains (n = 11) | TRB resistant strains (n = 9) | |
| Fluconazole | 33.13 | 30.05 | 37.33 |
| Itraconazole | 0.16 | 0.17 | 0.15 |
| Voriconazole | 0.25 | 0.25 | 0.25 |
| Ketoconazole | 0.31 | 0.32 | 0.29 |
| Terbinafine | 0.67 | 0.05* | > 16.00* |
| Griseofulvin | 3.48 | 2.92 | 4.32 |
| Ciclopirox olamine | 0.71 | 0.73 | 0.68 |
| Naftifine | 1.75 | 0.17* | 29.63* |
| Amorolfine | 0.12 | 0.09* | 0.17* |
Nine out of 20 strains (45%) were resistant to TRB (Table 1), all of them having an MIC-value of 16 mg/L or higher (as this was the upper concentration limit of the AST). These values exceed the WT-UL value established by Arendrup et al., which is set on 0.25 mg/L for terbinafine [19]. These results are in line with the observations during the screening test. At three to four days of incubation on the screening medium, growing colonies could be seen on the TRB containing medium for all TRB resistant strains, even for the slower growing strains like IHEM 28394, while none were detected at the plates incubated with susceptible strains (Fig. 1). After seven days, all TRB resistant strains were growing profusely, while the fungal growth was still zero for the susceptible strains.
For the other three antifungal agents with a WT-UL value, i.e. itraconazole, voriconazole and amorolfine (with values of 1.0, 2.0 and 1.0 mg/L respectively), all of the tested strains were considered susceptible.
When separating the TRB resistant and susceptible strains from each other and calculating the GM MIC-values for these two groups (Table 2), a clear increase in MIC-value could be spotted in resistant strains for fluconazole, griseofulvin, naftifine and amorolfine, with the difference in GMs being significant for naftifine and amorolfine (p = 0.05). With the exception of fluconazole, there is no noticeable difference in MIC value between TRB resistant and susceptible strains for the triazole antifungal drugs and ciclopirox olamine.
In the TRB resistant strains, the amino acid substitutions F397L (n = 8) and L393F (n = 1) could be observed, caused by SQLE missense mutations T1189C, C1191A or A1179C. Both substitutions F397L and L393F were absent in all 11 TRB susceptible strains. Two of the susceptible T. indotineae strains did not show any mutations in SQLE, while the remaining nine strains all contained the amino acid substitution A448T, caused by DNA mutation G134A. One susceptible strain (IHEM28397) had a silent amino acid substitution. There was one TRB resistant strain (IHEM 28395) that showed both the F397L and A448T substitutions in the SQLE protein.
MALDI-TOF MS
BCCM/IHEM Database
After comparing the obtained spectra of the 20 tested strains with the BCCM/IHEM database, 100% of the strains was correctly identified on species-level as T. indotineae. An overall mean best-match log score of 2.34 ± 0.16 was observed, with mean log scores of 2.35 ± 0.16 and 2.32 ± 0.17 for TRB susceptible and resistant strains respectively (no significant difference). The first three given best-match reference strains were T. indotineae strains for each tested strain. At the mass range and settings of the MALDI-TOF MS instrument, no distinction between TRB susceptible and resistant strains could be made by analyzing the best matches (Fig. 2).
Fig. 2.
Column charts of the best-matched reference strains of the T. indotineae strains. A Best-match reference strains obtained with the in-house BCCM/IHEM library. For each strain, four spots were identified by MALDI-TOF MS, each spot linked with its best-match reference strain. The best-match reference strain was considered TRB resistant when at least 3 out of 4 spots had a TRB resistant best-match (green), and vice versa for TRB susceptible strains (yellow). When a strain had two spots with a TRB susceptible best-match and two spots with a TRB resistant best-match, a 50/50 ratio TRB susceptible and resistant best-match strains was noted (blue). B Best-match reference strains obtained with the MSI database. For this database, the reference strain with the highest score was taken into account (green if it was TRB resistant and yellow if it was susceptible). Susceptibility to TRB was unknown for some reference strains (blue).
MSI V2.0 Database
Using the MSI platform, 95% of the tested T. indotineae strains were correctly and reliably identified on species-level (index of trust A). While the remaining 5% was also correctly identified as T. indotineae, the identification was only considered reliable on genus-level (index of trust B). The mean score of all strains was 58.68 ± 5.75, with 58.29 ± 6.04 and 58.99 ± 5.77 for TRB resistant and susceptible strains. Similar to the BCCM/IHEM database, a differentiation between TRB resistant and sensitive strains could not be made by MALDI-TOF MS (Fig. 2).
Discussion
A screening medium could be a useful tool in the determination of possible TRB resistance. This method can be seen as a fast first screening step before performing thorough antifungal susceptibility testing. The EUCAST AST protocol can be expensive and time-consuming: for dermatophytes like T. indotineae, a growing period of five to seven days before inoculation and an incubation period of two to five days after inoculation are required [25]. Using this screening medium, resistance to TRB could be detected within four days, while performing AST takes minimum a week, in all probability even longer. Nevertheless, in order to have a complete overview on susceptibility profiles and the evolution of TRB resistance levels, thorough AST using the EUCAST standardized method remains primordial.
When performing EUCAST AST on the twenty T. indotineae strains, nine strains (45%) were considered resistant to terbinafine. Eight of them contained the amino acid substitution F397, of which earlier research has shown that it is known to contribute to TRB resistance in T. indotineae [13, 26, 27]. In one of the resistant strains, amino acid substitution L393F was spotted, which has also already been observed in TRB resistant T. indotineae strains [12, 13, 26].
Aside from terbinafine, the TRB resistant strains showed increased MIC-values for naftifine as well. Naftifine is, like terbinafine, an allylamine which inhibits squalene epoxidase and thus, ergosterol production, which is a necessary component for fungal cell membranes. As naftifine exhibits the same mode of action as terbinafine, cross-resistance of these two antifungal agents is suspected. This phenomenon has been observed previously by Mukherjee et al. [15] for T. rubrum, who also described cross-resistance with other squalene epoxidase inhibitors such as butenafine and tolnaftate. In research by Rudramurthy et al. [28], the F397L substitution caused elevated MIC-values for naftifine in T. rubrum strains, also causing cross-resistance to TRB.
While T. indotineae TRB resistant strains were not declared resistant to amorolfine when considering the WT-UL values established by EUCAST, a significant increase in MIC-value could be observed in comparison with TRB susceptible strains. Amorolfine is an morpholine antifungal drug, inhibiting ergosterol production by interfering with Δ14-sterol reductase and Δ8→7 -isomerase [29], which is a different mode of action than TRB’s. Nevertheless, resistance to both naftifine and TRB has been described in C. glabrata [30, 31], although the resistance has been linked to overexpression of ATP-binding cassette (ABC) transporter genes instead of SQLE mutations. Fungal ABC transporters can act as efflux pumps for several antifungal drugs, providing resistance of the fungus [32, 33]. Ghelardi et al. [31] made notion of cross-resistance of amorolfine resistant T. rubrum strains to terbinafine, also mentioning overexpression of ABC transporters as the most probable explanation. Aside from ABC transporter overexpression, the observed SQLE mutations could not only have impacted squalene epoxidase, but other steps further in the ergosterol synthesis as well, leading to an increase in MIC-values.
There was no significant increase in MIC-values for all azole antifungal drugs when comparing TRB resistant strains to susceptible ones, although elevated values could be observed for fluconazole. Nine of the eleven TRB susceptible strains contained the A448T amino acid substitution. This substitution is known to cause increased MIC-values for triazole antifungal drugs, but there were no significantly elevated values observed in this research. These results are in line with the findings of Kong et al. [27]. They showed that the A448T substitution does not cause higher MIC-values for triazoles on its own, but it can lead to TRB resistance when present together with substitution F397L.
MALDI-TOF MS is known for its accurate and fast method for identifications of fungal species, which makes it a frequently used alternative in laboratories for identification by morphology or molecular sequencing. Morphology-based identification is still considered the conventional method for identification of fungi, but it can be time-consuming. This is especially the case for dermatophytes, because the fungus often needs to be cultured and grown for a sufficient amount of time before distinctive morphological characteristics can be seen under the microscope. Moreover, highly skilled staff is necessary to distinguish the features that are characteristic for each species [21]. This is especially the case for closely related species such as T. indotineae, which is phenotypically similar to T. mentagrophytes/T. interdigitale. Recently, Normand et al. [23] highlighted the capacity of the online MSI-2 application to correctly identify T. indotineae using MALDI-TOF MS. In this study, we evaluated the BCCM/IHEM in-house library for identification of twenty T. indotineae strains. Each isolate was correctly identified on species-level, while the library contained several reference spectra of T. mentagrophytes and T. interdigitale as well. When a self-managed in-house database is not available or does not give the desired accuracy of identification, the online and free MSI V2.0 tool can be used. Using this platform, 100% of the strains were correctly identified as T. indotineae, of which 95% were considered reliable on the species-level (level of trust A).
When analyzing the reference spectra concurring with the highest identification scores for the tested T. indotineae strains, no relation could be found between reference spectra of TRB resistant strains and spectra of resistant test strains. The same was true for TRB susceptible strains. This means that even if the mean of the best-match log score of a T. indotineae strain originates from a resistant strain, no confirmation can be given that the tested strain is resistant as well. This could possibly be due to the lack of range of analysis of the Microflex LT, since the observed TRB resistance is often the consequence of a single mutation in SQLE. In the future, with advanced specificity or detection, spotting resistance could be possible by using the MALDI-TOF MS technique. In this way, identification and resistance screening could be performed at the same time, using only one lab technique. There are several studies testing the capability of MALDI-TOF MS to detect resistance to antifungal drugs in fungi. In some researches, comparison between mass spectra of fungi incubated on different concentrations of antifungal drugs is used to obtain a composite correlation index, of which its value indicates if antifungal resistance is present or not [34–36]. A second technique is antifungal susceptibility testing by the means of the MALDI Biotyper antibiotic susceptibility test rapid assay (MBT ASTRA), which is a phenotypic assay comparing fungal growth after incubation on different concentrations of antifungal drugs by using the area under the curve of the obtained mass spectra [36, 37]. Especially the latter technique has shown some promising results in some Candida species.
Conclusion
In conclusion, this research demonstrated that a screening medium consisting of Sabouraud agar containing TRB could screen TRB resistance in T. indotineae strains in four days, which can be considered as a rapid first screening before performing broth microdilution antifungal susceptibility testing or when such type of analysis is not possible. After antifungal susceptibility testing, significantly elevated MIC-values were observed in TRB resistant T. indotineae strains for naftifine and amorolfine, raising the possibility of cross-resistance. The observed TRB resistance was caused by point mutations in SQLE, mainly resulting in amino acid substitutions F397L and L393F, while amino acid substitution A448T does not seem to cause azole resistance in T. indotineae when no other substitutions are present. Additionally, this study demonstrated the strength of MALDI-TOF MS as a reliable tool for the identification of T. indotineae strains, as it is able to distinguish them from closely related species T. interdigitale and T. mentagrophytes. Nevertheless, a distinction between TRB resistant and susceptible strains could not be made by this spectrometric technology.
Author Contributions
RDP: main author, study design and conceptualization, methodology, experimental laboratorial work, data analysis, ACN: study design and conceptualization, methodology, experimental laboratorial work, paper review, SU: experimental laboratorial work, paper review, RP: supervision, PN: paper review, supervision, AP: study design and conceptualization, paper review, supervision.
Funding
This work was funded by Sciensano. The authors declare that no other funds, grants, or support were received during the preparation of this manuscript.
Declarations
Conflict of interest
We know of no conflicts of interest associated with this publication and there has been no significant financial support for this work that could have influenced its outcome.
Footnotes
Publisher's Note
Springer Nature remains neutral with regard to jurisdictional claims in published maps and institutional affiliations.
References
- 1.Weitzman I, Summerbell RC. The dermatophytes. Clin Microbiol Rev. 1995;8(2):240–259. doi: 10.1128/CMR.8.2.240. [DOI] [PMC free article] [PubMed] [Google Scholar]
- 2.Hainer BL. Dermatophyte Infections. Am Fam Physician. 2003;67(1):101–109. [PubMed] [Google Scholar]
- 3.Havlickova B, Czaika VA, Friedrich M. Epidemiological trends in skin mycoses worldwide. Mycoses. 2008;51(s4):2–15. doi: 10.1111/j.1439-0507.2008.01606.x. [DOI] [PubMed] [Google Scholar]
- 4.Urban K, et al. The global, regional, and national burden of fungal skin diseases in 195 countries and territories: a cross-sectional analysis from the global burden of disease study 2017. JAAD Int. 2020;2:22–27. doi: 10.1016/j.jdin.2020.10.003. [DOI] [PMC free article] [PubMed] [Google Scholar]
- 5.Benedict K, Jackson BR, Chiller T, Beer KD. Estimation of direct healthcare costs of fungal diseases in the United States. Clin Infect Dis. 2019;68(11):1791–1797. doi: 10.1093/cid/ciy776. [DOI] [PMC free article] [PubMed] [Google Scholar]
- 6.Gupta AK, Venkataraman M, Hall DC, Cooper EA, Summerbell RC. The emergence of Trichophyton indotineae: Implications for clinical practice. Int J Dermatol. 2022 doi: 10.1111/ijd.16362. [DOI] [PubMed] [Google Scholar]
- 7.Nenoff P, et al. The current Indian epidemic of superficial dermatophytosis due to Trichophyton mentagrophytes—A molecular study. Mycoses. 2019;62(4):336–356. doi: 10.1111/myc.12878. [DOI] [PubMed] [Google Scholar]
- 8.Kano R, et al. Trichophyton indotineae sp. nov.: a new highly terbinafine-resistant anthropophilic dermatophyte species. Mycopathologia. 2020;185(6):947–958. doi: 10.1007/s11046-020-00455-8. [DOI] [PubMed] [Google Scholar]
- 9.Tang C, et al. Taxonomy of the Trichophyton mentagrophytes/T. interdigitale species complex harboring the highly virulent, multiresistant genotype T. indotineae. Mycopathologia. 2021;186(3):315–326. doi: 10.1007/s11046-021-00544-2. [DOI] [PMC free article] [PubMed] [Google Scholar]
- 10.Uhrlaß S, et al. Trichophyton indotineae—an emerging pathogen causing recalcitrant dermatophytoses in India and worldwide—a multidimensional perspective. J Fungi (Basel) 2022;8(7):757. doi: 10.3390/jof8070757. [DOI] [PMC free article] [PubMed] [Google Scholar]
- 11.Singh A, et al. A unique multidrug-resistant clonal Trichophyton population distinct from Trichophyton mentagrophytes/Trichophyton interdigitale complex causing an ongoing alarming dermatophytosis outbreak in India: genomic insights and resistance profile. Fungal Genet Biol. 2019 doi: 10.1016/j.fgb.2019.103266. [DOI] [PubMed] [Google Scholar]
- 12.Nenoff P, et al. Spread of terbinafine-resistant Trichophyton mentagrophytes Type VIII (India) in Germany–‘The tip of the iceberg? J Fungi. 2020;6(4):207. doi: 10.3390/jof6040207. [DOI] [PMC free article] [PubMed] [Google Scholar]
- 13.Sacheli R, Hayette M-P. Antifungal Resistance in Dermatophytes: genetic considerations, clinical presentations and alternative therapies. J Fungi. 2021;7(11):983. doi: 10.3390/jof7110983. [DOI] [PMC free article] [PubMed] [Google Scholar]
- 14.Jabet A, et al. Extensive dermatophytosis caused by terbinafine-resistant Trichophyton indotineae, France. Emerg Infect Dis. 2022;28(1):229–233. doi: 10.3201/eid2801.210883. [DOI] [PMC free article] [PubMed] [Google Scholar]
- 15.Mukherjee PK, Leidich SD, Isham N, Leitner I, Ryder NS, Ghannoum MA. Clinical Trichophyton rubrum strain exhibiting primary resistance to terbinafine. Antimicrob Agents Chemother. 2003;47(1):82–86. doi: 10.1128/AAC.47.1.82-86.2003. [DOI] [PMC free article] [PubMed] [Google Scholar]
- 16.Yamada T, et al. Terbinafine resistance of trichophyton clinical isolates caused by specific point mutations in the squalene epoxidase gene. Antimicrob Agents Chemother. 2017;61(7):e00115–e117. doi: 10.1128/AAC.00115-17. [DOI] [PMC free article] [PubMed] [Google Scholar]
- 17.Moreno-Sabater A, et al. Terbinafine resistance in dermatophytes: a french multicenter prospective study. J Fungi. 2022;8(3):220. doi: 10.3390/jof8030220. [DOI] [PMC free article] [PubMed] [Google Scholar]
- 18.Arendrup MC, et al. Multicentre validation of a EUCAST method for the antifungal susceptibility testing of microconidia-forming dermatophytes. J Antimicrob Chemother. 2020;75(7):1807–1819. doi: 10.1093/jac/dkaa111. [DOI] [PubMed] [Google Scholar]
- 19.Arendrup MC, et al. Comment on: multicentre validation of a EUCAST method for the antifungal susceptibility testing of microconidia-forming dermatophytes. J Antimicrob Chemother. 2022;77(4):1209–1210. doi: 10.1093/jac/dkac004. [DOI] [PubMed] [Google Scholar]
- 20.Cassagne C, et al. Mould routine identification in the clinical laboratory by matrix-assisted laser desorption ionization time-of-flight mass spectrometry. PLoS ONE. 2011;6(12):e28425. doi: 10.1371/journal.pone.0028425. [DOI] [PMC free article] [PubMed] [Google Scholar]
- 21.L’Ollivier C, Ranque S. MALDI-TOF-based dermatophyte identification. Mycopathologia. 2017;182(1):183–192. doi: 10.1007/s11046-016-0080-x. [DOI] [PubMed] [Google Scholar]
- 22.Nenoff P, et al. MALDI-TOF mass spectrometry—a rapid method for the identification of dermatophyte species. Med Mycol. 2013;51(1):17–24. doi: 10.3109/13693786.2012.685186. [DOI] [PubMed] [Google Scholar]
- 23.Normand A-C, et al. MALDI-TOF mass spectrometry online identification of Trichophyton indotineae using the MSI-2 application. J Fungi. 2022;8(10):1103. doi: 10.3390/jof8101103. [DOI] [PMC free article] [PubMed] [Google Scholar]
- 24.Normand AC, et al. Validation of a new web application for identification of fungi by use of matrix-assisted laser desorption ionization-time of flight mass spectrometry. J Clin Microbiol. 2017;55(9):2661–2670. doi: 10.1128/JCM.00263-17. [DOI] [PMC free article] [PubMed] [Google Scholar]
- 25.Arendrup MC, Kahlmeter G, Guinea J, Meletiadis J. How to: perform antifungal susceptibility testing of microconidia-forming dermatophytes following the new reference EUCAST method E.Def 11.0, exemplified by Trichophyton. Clin Microbiol Infect. 2021;27(1):55–60. doi: 10.1016/j.cmi.2020.08.042. [DOI] [PubMed] [Google Scholar]
- 26.Singh A, et al. High terbinafine resistance in Trichophyton interdigitale isolates in Delhi, India harbouring mutations in the squalene epoxidase gene. Mycoses. 2018;61(7):477–484. doi: 10.1111/myc.12772. [DOI] [PubMed] [Google Scholar]
- 27.Kong X, et al. Antifungal susceptibility and mutations in the squalene epoxidase gene in dermatophytes of the Trichophyton mentagrophytes species complex | antimicrobial agents and chemotherapy. Antimicrob Agents Chemother. 2021;65(8):10–1128. doi: 10.1128/AAC.00056-21. [DOI] [PMC free article] [PubMed] [Google Scholar]
- 28.Rudramurthy SM, et al. Mutation in the squalene epoxidase gene of Trichophyton interdigitale and Trichophyton rubrum associated with allylamine resistance. Antimicrob Agents Chemother. 2018;62(5):e02522–e2617. doi: 10.1128/AAC.02522-17. [DOI] [PMC free article] [PubMed] [Google Scholar]
- 29.Polak A. Preclinical data and mode of action of amorolfine. Dermatology. 1992;184(Suppl 1):3–7. doi: 10.1159/000247588. [DOI] [PubMed] [Google Scholar]
- 30.Vanden Bossche H. Mechanisms of antifungal resistance. Rev Iberoam de Micol. 1997;14(2):44–49. [PubMed] [Google Scholar]
- 31.Ghelardi E, et al. Potential of ergosterol synthesis inhibitors to cause resistance or cross-resistance in Trichophyton rubrum. Antimicrob Agents Chemother. 2014;58(5):2825–2829. doi: 10.1128/AAC.02382-13. [DOI] [PMC free article] [PubMed] [Google Scholar]
- 32.Maranhão FCA, Paião FG, Fachin AL, Martinez-Rossi NM. Membrane transporter proteins are involved in Trichophyton rubrum pathogenesis. J Med Microbiol. 2009;58(2):163–168. doi: 10.1099/jmm.0.002907-0. [DOI] [PubMed] [Google Scholar]
- 33.Mishra NN, et al. Pathogenicity and drug resistance in Candida albicans and other yeast species. A review. Acta Microbiol Immunol Hung. 2007;54(3):201–235. doi: 10.1556/AMicr.54.2007.3.1. [DOI] [PubMed] [Google Scholar]
- 34.De Carolis E, et al. Use of matrix-assisted laser desorption ionization-time of flight mass spectrometry for caspofungin susceptibility testing of Candida and Aspergillus species. J Clin Microbiol. 2012;50(7):2479–2483. doi: 10.1128/JCM.00224-12. [DOI] [PMC free article] [PubMed] [Google Scholar]
- 35.Vella A, et al. Rapid antifungal susceptibility testing by matrix-assisted laser desorption ionization-time of flight mass spectrometry analysis. J Clin Microbiol. 2013;51(9):2964–2969. doi: 10.1128/JCM.00903-13. [DOI] [PMC free article] [PubMed] [Google Scholar]
- 36.Florio W, Tavanti A, Ghelardi E, Lupetti A. MALDI-TOF MS applications to the detection of antifungal resistance: state of the art and future perspectives. Front Microbiol. 2018;9:2577. doi: 10.3389/fmicb.2018.02577. [DOI] [PMC free article] [PubMed] [Google Scholar]
- 37.Vatanshenassan M, et al. Proof of concept for MBT ASTRA, a rapid matrix-assisted laser desorption ionization-time of flight mass spectrometry (MALDI-TOF MS)-based method to detect caspofungin resistance in Candida albicans and Candida glabrata. J Clin Microbiol. 2018;56(9):e00420–e518. doi: 10.1128/JCM.00420-18. [DOI] [PMC free article] [PubMed] [Google Scholar]